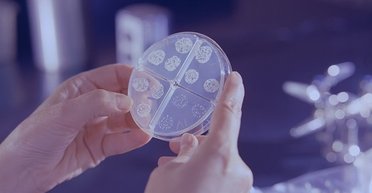
У 20 разів більше смертей: світ готується до нової загадкової пандемії "Хвороби X"

Термоядерна енергія поки що є мрією для фізиків, хоча вона могла б стати справжнім порятунком для людства.
-
-
Пасажири літака, який впав у горах у Південній Америці, уклали договір, що ті, хто виживе, зможуть з'їсти тих, хто загинув.
-
Здається, що це просте питання, але визначити, яка планета розташована найближче до Землі, напрочуд складно.
-
Часові парадокси цілком можуть зробити подорож у часі неможливою. Теорія відносності Ейнштейна показала, що простір і час тісніше пов'язані, ніж передбачалося раніше.
-
Розвідниця Ярина Чорногуз вважає, що вмотивованих служити в армії жінок в Україні достатньо і їй гидко, що норма захищати жінками Батьківщину не закріплена законодавчо.
-
Дві мумії, як передбачалося, інопланетян, було виявлено в аеропорту Перу, але аналіз показав, що нічого позаземного в них немає.
-
Термін "Хвороба Х", який з'явився кілька років тому, використовують науковці для заохочення розроблення контрзаходів, включно з вакцинами і тестами, які можна буде використовувати в разі майбутнього спалаху захворювання.
-
Новий літак призначений для подолання звукового бар'єра без оглушливих звукових ударів, які зазвичай виникають у цей момент.
-
У 1969 році американцям вдалося виграти в "битві за Місяць" у колишнього СРСР, тепер замість цієї країни проти США "грає" Китай.
-
Автори нового дослідження пропонують хорошу альтернативу для хімічних ракетних двигунів.